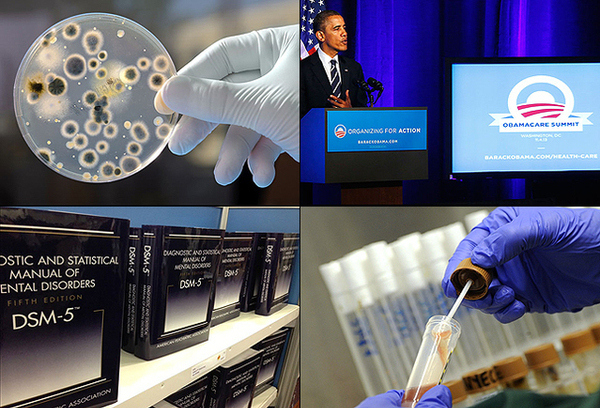
猴子换头手术成功4

首页>今日读图今日读图
猴子换头手术成功 盘点2015生物医学大事件
六、 癌症免疫治疗方法突飞猛进
安进溶癌病毒在美上市,其他多种免疫治疗药物先后上市并取得了非常不错的效果。这一领域也迅速成为医药公司重点投入和竞争的热点。
七、 火腿、香肠、肉干被列为致癌物
被列为致癌物的东西有许多,也是世界卫生组织的国际癌症研究所的份内工作。但是这次被列入的成员比较特殊,因为这是许多人的日常饮食。
八、 Springer公司大批撤回中国学者伪评审论文
几乎都是来自生物医学领域,几乎全部都是中国学者。这个事已经被大家和国际多个大媒体广泛讨论,丢人丢到全世界。不是热点也是热点的黑色话题。
九、 埃博拉疫苗成功
埃博拉是一个让人恐惧的疾病,人类使用疫苗能有效预防这一疾病给控制这一疾病带来了关键条件。这一点就可以说明其重要性。
十、 美国总统奥巴马提出精准医学
美国总统奥巴马在2015年国情咨文演讲中谈到了“人类基因组计划”(Human Genome Project)所取得的成果,并宣布了新的生物医学项目——精准医疗计划(Precision Medicine Initiative)。这是奥巴马总统继大脑研究计划后,再次利用年度国情咨文演讲的机会,发布生物医学研究的纲领性倡议。
编辑:杨岚
关键词:猴子换头手术成功 换头手术成功


中国制造助力孟加拉国首条河底隧道项目
澳大利亚猪肉产业协会官员看好进博会机遇
联合国官员说叙利亚约1170万人需要人道主义援助
伊朗外长扎里夫宣布辞职
中国南极中山站迎来建站30周年
联合国特使赴也门斡旋荷台达撤军事宜
以色列前能源部长因从事间谍活动被判11年监禁
故宫博物院建院94年来首开夜场举办“灯会”
法蒂玛·马合木提
王召明
王霞
辜胜阻
聂震宁
钱学明
孟青录
郭晋云
许进
李健
覺醒法師
吕凤鼎
贺铿
金曼
黄维义
关牧村
陈华
陈景秋
秦百兰
张自立
郭松海
李兰
房兴耀
池慧
柳斌杰
曹义孙
毛新宇
詹国枢
朱永新
张晓梅
焦加良
张连起
龙墨
王名
何水法
李延生
巩汉林
李胜素
施杰
王亚非
艾克拜尔·米吉提
姚爱兴
贾宝兰
谢卫
汤素兰
黄信阳
张其成
潘鲁生
冯丹藜
艾克拜尔·米吉提
袁熙坤
毛新宇
学诚法师
宗立成
梁凤仪
施 杰
张晓梅


